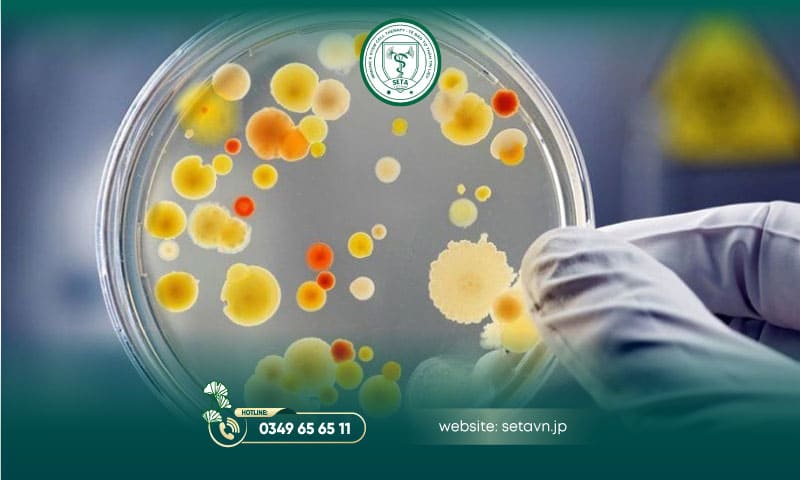
Nuôi Cấy Tế Bào Sinh Dưỡng 13 Nuôi cấy tế bào sinh dưỡng - SETA Việt Nam

Môi Trường Nuôi Cấy Tế Bào Gốc: Những Lưu Ý Quan Trọng
9 Tháng 4, 2025Guide complet du casino en ligne – Tout ce que vous devez savoir pour jouer en toute sécurité et maximiser vos gains
10 Tháng 4, 2025Nuôi cấy tế bào sinh dưỡng không chỉ là một công cụ nghiên cứu quan trọng mà còn là nền tảng cho những bước tiến đột phá trong y học và công nghệ sinh học. Từ khả năng tái tạo mô, sản xuất vắc xin, đến thử nghiệm thuốc và y học cá nhân hóa, tiềm năng của công nghệ này mở ra những cơ hội mới trong điều trị bệnh lý phức tạp. Nếu bạn vẫn chưa rõ tế bào sinh dưỡng là gì, cách nuôi cấy tế bào sinh dưỡng như thế nào, hãy khám phá những thông tin thú vị và chi tiết trong bài viết này nhé!
Tế bào sinh dưỡng là gì?
Tế bào sinh dưỡng, hay còn gọi là tế bào soma, là các tế bào không tham gia vào quá trình sinh sản (khác với tế bào sinh dục như trứng và tinh trùng), có khả năng phân chia và phát triển thành các mô hoặc cơ quan trong cơ thể.
Đặc điểm của tế bào sinh dưỡng:
- Bản chất lưỡng bội (Diploid): Tế bào sinh dưỡng có bộ nhiễm sắc thể lưỡng bội (2n), tức là chúng có hai bộ nhiễm sắc thể (một bộ từ mẹ và một bộ từ cha). Điều này khác biệt so với tế bào sinh dục (tế bào trứng và tinh trùng), vốn chỉ có một bộ nhiễm sắc thể (n). Bản chất lưỡng bội của tế bào sinh dưỡng giúp duy trì sự ổn định về mặt di truyền qua các thế hệ, đồng thời cho phép tế bào sao chép chính xác khi phân chia.
- Khả năng nguyên phân: Tế bào sinh dưỡng có khả năng tự phân chia để tạo ra các tế bào con giống hệt tế bào mẹ. Quá trình nguyên phân này là yếu tố quan trọng trong sự phát triển, tái tạo và sửa chữa mô của cơ thể.
- Chức năng đa dạng: Tế bào sinh dưỡng không chỉ có khả năng phân chia mà còn thực hiện nhiều chức năng quan trọng trong cơ thể. Các chức năng này bao gồm:
- Tái tạo mô: Khi có tổn thương hoặc mất mát mô, tế bào sinh dưỡng phân chia và biệt hóa thành các tế bào cần thiết để thay thế những tế bào đã mất. Ví dụ, tế bào sinh dưỡng trong da có thể phân chia để thay thế tế bào da bị thương.
- Biệt hóa thành các tế bào chuyên biệt: Tế bào sinh dưỡng có khả năng biệt hóa thành các loại tế bào đặc thù tùy thuộc vào vị trí và vai trò trong cơ thể.

Các loại tế bào sinh dưỡng?
Tế bào sinh dưỡng được phát hiện hầu hết ở cả cơ thể thực vật và động vật.
Tế bào sinh dưỡng thực vật
- Tế bào mô phân sinh: có khả năng phân chia liên tục để tạo ra các tế bào mới, giúp cây phát triển về chiều dài và chiều rộng.
- Tế bào mô mềm: Tế bào này có chức năng lưu trữ, quang hợp và vận chuyển nước, khoáng chất.
- Tế bào mạch gỗ: chuyên vận chuyển nước và khoáng chất từ rễ lên các bộ phận khác của cây.
Tế bào sinh dưỡng động vật
- Tế bào cơ: Bao gồm cơ trơn, cơ tim và cơ vân, giúp cơ thể vận động và duy trì chức năng nội tạng.
- Tế bào thần kinh: Tiếp nhận và truyền tín hiệu đến và đi từ não và tủy sống.
- Tế bào máu: Bao gồm hồng cầu, bạch cầu và tiểu cầu, thực hiện các chức năng vận chuyển oxy, miễn dịch và đông máu.
Điều kiện cần thiết để nuôi cấy tế bào sinh dưỡng là gì?
Nuôi cấy tế bào là phương pháp kỹ thuật trong sinh học, trong đó các tế bào sống được tách ra từ cơ thể động vật, thực vật và được nuôi trong môi trường nhân tạo bên ngoài cơ thể (in vitro).
Các yêu cầu cơ bản để tế bào phát triển tối ưu:
- Môi trường nuôi cấy: Môi trường nuôi cấy tế bào sinh dưỡng đóng vai trò quan trọng trong việc duy trì sự sống và phát triển của tế bào trong điều kiện nhân tạo. Những môi trường này cung cấp các chất dinh dưỡng cần thiết như amino acid, glucose, vitamin, và khoáng chất, giúp tế bào sinh trưởng và phát triển hiệu quả.

Kỹ thuật viên SETA Việt Nam chuẩn bị môi trường nuôi cấy
- Phòng nuôi cấy: Phòng nuôi cấy tế bào là một không gian chuyên biệt, được trang bị thiết bị hiện đại để tạo ra môi trường tối ưu cho sự phát triển và nghiên cứu tế bào. Các yếu tố như nhiệt độ, độ ẩm và áp suất được kiểm soát chặt chẽ, đảm bảo tế bào sinh trưởng tốt. Đồng thời, phòng cần đáp ứng các yêu cầu về vệ sinh và tiệt trùng, sử dụng hệ thống lọc HEPA để ngăn ngừa nhiễm bẩn từ vi khuẩn, nấm và các tác nhân gây nhiễm bệnh từ môi trường bên ngoài.

Phòng nuôi cấy tế bào tại SETA Việt Nam
- Thiết bị, máy móc: Để đạt được sự phát triển tối ưu trong nuôi cấy tế bào, các thiết bị hiện đại và chất lượng là điều không thể thiếu trong mọi phòng thí nghiệm. Tủ ấm CO₂ là thiết bị cốt lõi, tạo ra môi trường lý tưởng với nhiệt độ thường được duy trì ở 37°C, tương tự như nhiệt độ cơ thể người và nồng độ CO2 được giữ ở mức 5% để duy trì pH của môi trường nuôi cấy giúp tế bào phát triển mạnh mẽ.
Cùng với đó, tủ an toàn sinh học bảo vệ tế bào và nhân viên khỏi vi sinh vật bên ngoài, đảm bảo một không gian làm việc sạch sẽ và an toàn.
Ngoài ra, kính hiển vi là công cụ giúp chúng ta quan sát hình thái và hành vi của tế bào trong môi trường nuôi cấy. Máy ly tâm cho phép tách biệt nhanh chóng các thành phần trong mẫu tế bào. Máy đếm tế bào giúp xác định mật độ tế bào, hỗ trợ đánh giá sức khỏe và sự sinh trưởng của tế bào.
Phương pháp nuôi cấy tế bào sinh dưỡng
Các phương pháp nuôi cấy tế bào thường được phân loại theo nhiều tiêu chí khác nhau. Trong đó, phân loại theo kỹ thuật nuôi cấy bao gồm ba phương pháp phổ biến: nuôi cấy đơn lớp, nuôi cấy lỏng và nuôi cấy 3D.
- Nuôi cấy đơn lớp là một phương pháp thông dụng nhất, trong đó tế bào được nuôi cấy trên bề mặt của đĩa petri hoặc bình nuôi cấy, tạo thành một lớp tế bào đơn lẻ, cho phép dễ dàng quan sát hình thái cũng như sự phát triển của của tế bào. Bởi vậy, phương pháp này là lựa chọn lý tưởng cho các thí nghiệm cơ bản, như thử nghiệm tác dụng của thuốc, phân tích di truyền và nghiên cứu cơ chế tế bào.
- Nuôi cấy lỏng là phương pháp nuôi cấy tế bào trong môi trường dinh dưỡng lỏng, cho phép tế bào phát triển tự do trong trạng thái lơ lửng. Kỹ thuật này tạo điều kiện lý tưởng cho sự trao đổi chất, tối ưu hóa tốc độ sinh trưởng và sản xuất sinh khối lớn. Nuôi cấy lỏng thường được áp dụng cho tế bào máu và tế bào miễn dịch, đóng vai trò quan trọng trong nghiên cứu sinh học và sản xuất vaccine, protein tái tổ hợp, cũng như các hợp chất sinh học khác.
- Ngày nay, Nuôi cấy 3D trở thành một phương pháp tiên tiến trong nghiên cứu tế bào. Trong nuôi cấy 3D, tế bào được phát triển trong một cấu trúc ba chiều, thường sử dụng các vật liệu nền như hydrogel hoặc scaffold sinh học. Phương pháp này mô phỏng tốt hơn các điều kiện in vivo, cho phép tạo ra các mô hình tế bào gần giống với mô thực tế trong cơ thể. Nuôi cấy 3D cũng giúp nghiên cứu các tương tác giữa các tế bào và môi trường một cách chính xác hơn, từ đó cung cấp nền tảng vững chắc cho nghiên cứu thử nghiệm thuốc và phát triển liệu pháp mới.
Nuôi cấy tế bào sinh dưỡng được ứng dụng trong y học như thế nào?
Trong lĩnh vực y học, nuôi cấy tế bào có một số ứng dụng nổi bật:
- Nghiên cứu và phát triển thuốc: Nuôi cấy tế bào được sử dụng để kiểm tra tác dụng của các loại thuốc mới, giúp xác định tính an toàn và hiệu quả của chúng trước khi thử nghiệm trên người.
- Sản xuất vắc-xin: Vaccine có thể được sản xuất bằng cách nuôi cấy virus trong tế bào, giúp tạo ra sản phẩm an toàn và hiệu quả.

- Nghiên cứu/ điều trị ung thư: Nuôi cấy tế bào ung thư giúp nghiên cứu cơ chế bệnh và phát triển các liệu pháp điều trị nhắm vào các tế bào ung thư, ví dụ như liệu pháp miễn dịch.
- Phát triển mô hình bệnh: Tạo ra các mô hình tế bào và mô để nghiên cứu sự phát triển của bệnh và thử nghiệm các phương pháp điều trị mới.
Các thách thức và hạn chế trong nuôi cấy tế bào
Nuôi cấy tế bào là một kỹ thuật quan trọng trong nhiều nghiên cứu khoa học và y học, nhưng cũng gặp phải một số vấn đề và thử thách. Dưới đây là một số vấn đề thường gặp trong quá trình nuôi cấy tế bào:
- Nhiễm bẩn: Đây là một trong những vấn đề nghiêm trọng nhất trong nuôi cấy tế bào. Nhiễm bẩn có thể do vi khuẩn, nấm, virus hoặc các tế bào khác xâm nhập vào môi trường nuôi cấy. Nhiễm bẩn có thể làm giảm chất lượng mẫu, ảnh hưởng đến kết quả thí nghiệm và đôi khi làm hỏng toàn bộ quá trình nghiên cứu.
- Nguy cơ nhiễm chéo: Khi tế bào từ một môi trường nuôi cấy vô tình trộn lẫn với tế bào từ môi trường khác. Điều này có thể xảy ra do thao tác không chính xác hoặc bảo quản không đúng cách.
- Tế bào mất đặc tính sinh học theo thời gian: Sau nhiều lần cấy chuyền (passage), tế bào có thể thay đổi về hình thái, biểu hiện gen hoặc mất khả năng biệt hóa.
- Nguy cơ lão hóa: sau một số chu kỳ phân chia, tế bào có thể đạt đến giai đoạn lão hóa, không còn khả năng phân chia hoặc hoạt động như bình thường. Điều này có thể ảnh hưởng đến kết quả nghiên cứu, đặc biệt là khi nghiên cứu các dòng tế bào lâu dài.
- Chi phí cao: Các thiết bị, môi trường nuôi cấy và quy trình vận hành có thể đắt đỏ, gây áp lực về kinh phí cho các phòng thí nghiệm.
Hãy theo dõi chúng tôi để cập nhật những tin tức sức khoẻ mới nhất tại:
Fanpage: https://www.facebook.com/setavietnam
Youtube: https://www.youtube.com/@SETAVIETNAM
Tiktok: https://www.tiktok.com/@setavietnam
Địa chỉ: Tầng 2, Tháp A, Toà D2 – đường Giảng võ, TP Hà nội.
Hotline: 0349 65 65 11
Thời gian làm việc: Thứ 2 – Thứ 7: 8:00am – 6:00pm





